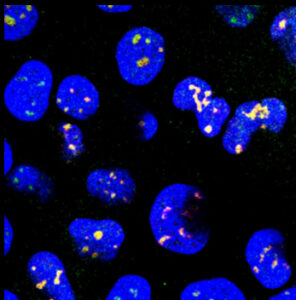

Targeting cellular structures called nuclear speckles could be a completely new approach for treating proteinopathies — diseases driven by abnormal accumulation of misfolded proteins — such as Alzheimer’s, Parkinson’s and prion diseases, according to new research publishing in Nature Communications led by the University of Pittsburgh.
“Our research is painting a picture where dysregulation of nuclear speckles is important for neuron degeneration in the context of many diseases,” said senior author Dr. Bokai Zhu, assistant professor in Pitt’s Department of Medicine and the Aging Institute. “The concept of rejuvenating nuclear speckles to treat these diseases is completely novel, but I believe it’s the next frontier of neurodegenerative research.”
Cell nuclei with chromatin—a mixture of DNA and protein—shown in blue and nuclear speckles shown in yellow. Image credit: Zhu Lab
Nuclear speckles are structures within cell nuclei that regulate proper protein production, folding and degradation — a balance known as proteostasis. Zhu’s previous research found that nuclear speckle shape affects function: more spherical speckles were linked with worse proteostasis than irregularly shaped ones.
Hypothesizing that drugs that make nuclear speckles less round could treat proteinopathies, Zhu’s team screened hundreds of FDA-approved drugs. When they measured the effects on nuclear speckle sphericity, one stood out: pyrvinium pamoate, originally approved for treating pinworm infections.
And sure enough, pyrvinium pamoate improved proteostasis within cells in a dish, found first author Dr. William Dion, a former graduate student in Zhu’s lab.
“We were thrilled that our hypothesis was correct,” said Zhu. “This led us to ask: Does this drug work in disease models, and how does it work?”
Promising Disease Model Results
Zhu collaborated with Dr. Xu Chen, at UC San Diego, who studies tauopathies — diseases driven by tau protein buildup in the brain, causing memory, cognitive and locomotive deficits.
In mouse neurons expressing human tau, pyrvinium pamoate reduced the pathological protein by about 70%.
“Tau is a really difficult protein to degrade, so I didn’t think this experiment was going to work,” said Zhu. “But a week after starting my collaboration with Dr. Chen, I got a text message from her saying that she had collected some of the best data in her career.”
Human neurons carrying a frontotemporal dementia-associated tau mutation had abnormally shaped nuclear speckles and elevated tau levels. Led by Yuren Tao, a graduate student in Dr. Xu Chen’s lab, the researchers showed that low doses of the drug restored nuclear speckle shape and dramatically reduced tau levels without causing cellular stress or toxicity.
In fly models of tauopathy, locomotive symptoms can be measured by assessing climbing ability. Adding pyrvinium pamoate greatly improved climbing prowess in both larvae and adult flies — important evidence of the drug’s effectiveness in living creatures.
In experiments led by Dr. Yuanyuan Chen, assistant professor of ophthalmology at Pitt, the researchers used mouse retinas cultured in a dish to show that the drug held promise for treating retinitis pigmentosa, a disease caused by a faulty gene that leads to misfolding of the retinal protein rhodopsin, which clogs up the rod cells of the eye and causes progressive vision loss.
Unique Mechanism of Action
To understand how the drug works, Dr. Bennett Van Houten, professor in the Pitt Department of Pharmacology & Chemical Biology, led experiments with optical tweezers, which use lasers to precisely manipulate microscopic structures. Nuclear speckles were typically difficult to stretch because of high surface tension, but adding the drug dramatically lowered surface tension, making speckles easy to stretch and rupture.
According to Zhu, when nuclear speckles have lower surface tension, they become less round and spread out to make better contact with chromosomes, leading to greater production of genes regulating proteostasis.
“This was the killer experiment,” said Zhu. “Unlike most drugs, which target a specific receptor, pyrvinium pamoate acts by changing the surface tension of nuclear speckles. This is a totally new idea. Because nuclear speckles act globally on chromosomes, the drug can potentially alter the expression of hundreds of genes — which may be why it is so effective.”
Zhu hopes to move this research into clinical trials soon to test whether pyrvinium pamoate could effectively treat proteinopathies in humans.









